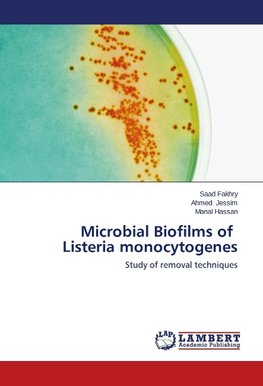
Microbial Biofilms of Listeria monocytogenes

-
 Anglický jazyk
Anglický jazyk
Microbial Biofilms of Listeria monocytogenes
Autor: Saad Fakhry
The presence of biofilm aroused increasing interest in the food business operators in what can be the cause of health problems, as well as of economic damage. The periodic detachment of bacterial cells from the biofilm, in fact, is a possible source of contamination... Viac o knihe
Na objednávku
35.15 €
bežná cena: 37.00 €
O knihe
The presence of biofilm aroused increasing interest in the food business operators in what can be the cause of health problems, as well as of economic damage. The periodic detachment of bacterial cells from the biofilm, in fact, is a possible source of contamination of work environments, and then the food by both spoilage germs and pathogens. Listeria monocytogenes, a ubiquitous germ, frequently isolated from processing environments and conveyed from foods of both animal and vegetable again. L. monocytogenes, once entry within an establishment is difficult to eradicate the remarkable ability to adaptation and survival even in the particularly difficult conditions. Numerous factors environment such as temperature, concentration of nutrients (especially simple sugars, amino acids, PO4), pH, type of contact surface and different stress response.
- Vydavateľstvo: LAP LAMBERT Academic Publishing
- Rok vydania: 2014
- Formát: Paperback
- Rozmer: 220 x 150 mm
- Jazyk: Anglický jazyk
- ISBN: 9783659578793












